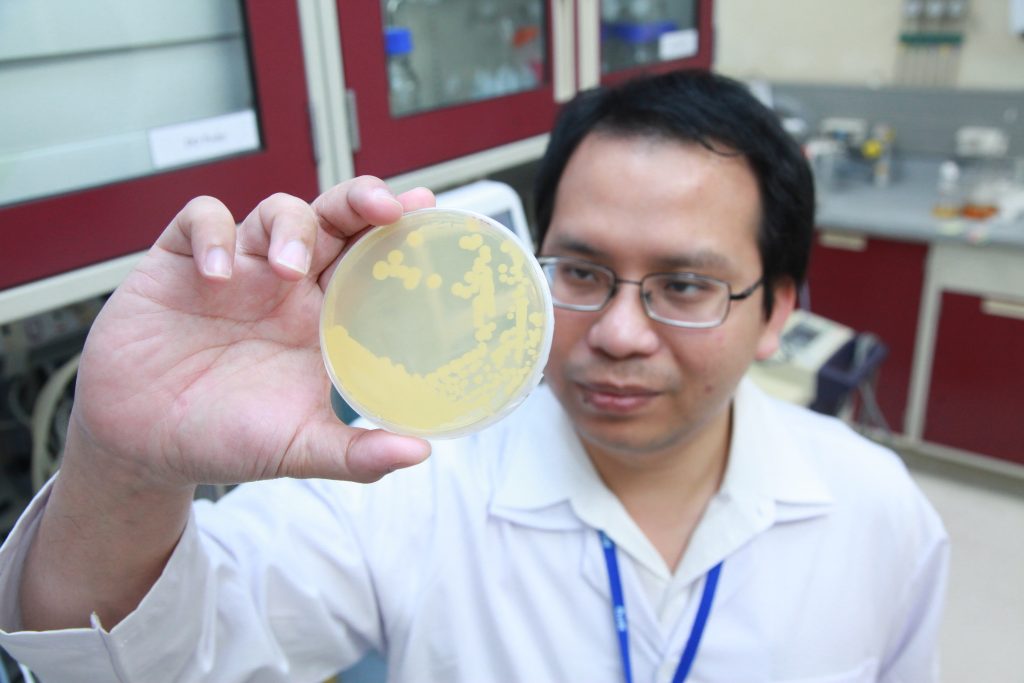

ปตท. จับมือ UBE ชูเทคโนโลยีการพัฒนาสายพันธุ์ยีสต์ทนร้อนที่ผ่านการวิจัยด้วยเทคโนโลยีชีวภาพขั้นสูง
นางสาวอรุณรัตน์ วุฒิมงคลชัย ผู้ช่วยกรรมการผู้จัดการใหญ่ สถาบันนวัตกรรม บริษัท ปตท. จำกัด (มหาชน) (ที่ 3 จากซ้าย) และนางสาวสุรียส โควสุรัตน์ กรรมการผู้จัดการใหญ่ บริษัท อุบล ไบโอ เอทานอล จำกัด (มหาชน) (ที่ 3 จากขวา) ร่วมลงนามในสัญญาการใช้เทคโนโลยียีสต์ InnoTherm-380GA ในกระบวนการผลิตเอทานอลเชิงพาณิชย์ ระหว่าง บริษัท ปตท. จำกัด (มหาชน) (ปตท.) และบริษัท อุบล ไบโอ เอทานอล จำกัด (มหาชน) (UBE) โดยมีนางสาววิวรรณ ธรรมมงคล ผู้จัดการฝ่ายวิจัยเทคโนโลยีชีวภาพและวัสดุ (ที่ 2 จากซ้าย) นางอัมพร สุดสงวน ผู้จัดการฝ่ายแผนกลยุทธ์และบริหารนวัตกรรม บริษัท ปตท. จำกัด (มหาชน) (ซ้าย) พร้อมด้วยนายชุณห์ โภไคศวรรย์ รองกรรมการผู้จัดการใหญ่ ฝ่ายบัญชีและการเงิน (ที่ 2 จากขวา) และนายวุฒิพงศ์ นิลผาย รองกรรมการผู้จัดการใหญ่ ธุรกิจเอทานอล บริษัท อุบล ไบโอ เอทานอล จำกัด (มหาชน) (ขวา) ร่วมเป็นสักขีพยาน โดยความร่วมมือนี้ เป็นการนำเทคโนโลยีชีวภาพขั้นสูงที่ผ่านการวิจัยโดยสถาบันนวัตกรรม ปตท. มาพัฒนาสายพันธุ์ยีสต์ทนร้อนเพื่อช่วยลดปริมาณการใช้เอนไซม์ย่อยแป้งในกระบวนการผลิตเอทานอลจากมันสำปะหลัง ส่งผลให้สามารถลดต้นทุนค่าใช้จ่ายด้านเอนไซม์ย่อยแป้งลง แต่ไม่ลดประสิทธิภาพการผลิต ทั้งยังเป็นการสนับสนุนการใช้เทคโนโลยีที่พัฒนาขึ้นโดยนักวิจัยไทย ลดการพึ่งพาการนำเข้าเทคโนโลยีจากต่างประเทศ อันเป็นการสร้างเสถียรภาพทั้งในด้านเทคโนโลยีและพลังงาน เพื่อช่วยขับเคลื่อนเศรษฐกิจของประเทศให้ยั่งยืนต่อไป